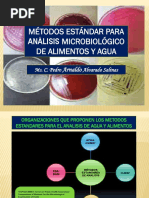

0% encontró este documento útil (0 votos)
139 vistas3 páginasInforme Control Microbiologico Del Agua
El documento describe un estudio de control microbiológico del agua que encontró E. coli en una muestra de agua tomada de una calle en Buenos Aires, Argentina. Los estudiantes cultivaron la muestra en placas y tubos para identificar la presencia de bacterias entéricas, y uno de los tubos dio positivo para enterobacterias detectadas por la presencia de burbujas.
Cargado por
Fede ParodiDerechos de autor
© © All Rights Reserved
Nos tomamos en serio los derechos de los contenidos. Si sospechas que se trata de tu contenido, reclámalo aquí.
Formatos disponibles
Descarga como DOCX, PDF, TXT o lee en línea desde Scribd
0% encontró este documento útil (0 votos)
139 vistas3 páginasInforme Control Microbiologico Del Agua
El documento describe un estudio de control microbiológico del agua que encontró E. coli en una muestra de agua tomada de una calle en Buenos Aires, Argentina. Los estudiantes cultivaron la muestra en placas y tubos para identificar la presencia de bacterias entéricas, y uno de los tubos dio positivo para enterobacterias detectadas por la presencia de burbujas.
Cargado por
Fede ParodiDerechos de autor
© © All Rights Reserved
Nos tomamos en serio los derechos de los contenidos. Si sospechas que se trata de tu contenido, reclámalo aquí.
Formatos disponibles
Descarga como DOCX, PDF, TXT o lee en línea desde Scribd